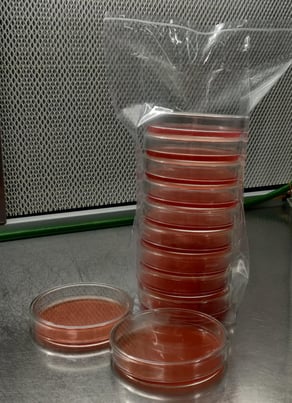

Store
To purchase spawns or cultures please call or whatsapp us on +91 88772 22229 or email us at info@tgef.in
All spawn and cultures are sold with cleanliness and viability guarantee, should you find your order to be unviable or contaminated please contact us. We do not assure survival of spawns or cultures due to weather conditions or mishandling by the courier company. Use your best judgement when placing an order.
Grain Spawn
Mushroom spawn is the crucial starting point for cultivating a wide variety of mushrooms. It's essentially a substrate inoculated with fungal mycelium, the thread-like network of cells that gives rise to mushrooms. This mycelium-rich material serves as the foundation for mushroom cultivation.
Agaricus bisporus (Button Mushroom)
Pleurotus ostreatus (Oyster Mushroom)
Lentinus edodes (Shiitake Mushroom)
Hericium erinaceus (Lions Mane Mushroom)
Calocybe indica (Milky Mushroom)
Auricularia polytricha (Wood Ear Mushroom)
Duration
Orders will be shipped within 5 days of order confirmation.
Cultures
Our cultures are sourced carefully from around the globe. These are then tested and only the best and highest yielding strains are put into production. These cultures can be used to inoculate anything from agar plates, grains, sterilized substrates, or even more culture of your own.
The cultures we sell are the ones we use. Each culture comes in Petri dish or in liquid culture form.
Duration
Orders will be shipped within 10 days of order confirmation.
Supplies
We now offer a comprehensive range of supplies designed to kickstart your mushroom growing venture. Following items are available to order:
Polypropylene Mushroom Grow Bags
Carbendazim
Formalin
Calcuim Carbonate
Calcium Sulphate
Rubber Bands
Unicorn Bags
Pre-Poured Agar Plates
Injection Ports and Vials
Syringe Filters